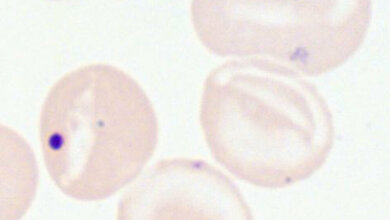
Howell-Jolly-Körperchen

Angeborene Anämien, ausgelöst durch Eisenstoffwechselstörungen, sind eine heterogene Erkrankungsgruppe, die verschiedene genetische Defekte als Auslöser haben kann. Im Rahmen des Projekts am Zentrum für Kinder- und Jugendmedizin konnte das Ärzteteam um Prof. Dr. Martina Muckenthaler und Prof. Dr. Andreas Kulozik in einer Spezialsprechstunde hochspezifische diagnostische Verfahren und das erbgutweite Screening nach noch unbekannten genetischen Ursachen etablieren. Das Team führte Transplantationen mit blutbildenden Stammzellen von Fremdspendern für die Behandlung der häufig auftretenden Sichelzellkrankheit und Thalassämien ein. Seit 2010 wurden bereits zwölf junge Patienten mit schweren Erkrankungsformen auf diese Weise behandelt und geheilt.
Erhebliche Fortschritte in Diagnostik und Behandlung
Die Auswirkungen der identifizierten Genfehler im Erbgut werden vorerst in Zell- und Tiermodellen abgeklärt. Dennoch konnte mithilfe der „Dietmar Hopp Stiftung“ eine Brücke zwischen den wissenschaftlichen Grundlagen und der klinischen Versorgung geschlagen werden. „Mit dieser Strategie haben wir erhebliche Fortschritte in der Diagnose und Behandlung von angeborenen Anämien und Eisenstoffwechselstörungen erzielt. Insbesondere bei Patienten mit bisher unbekannten genetischen Defekten ließ sich so die Therapie entscheidend verbessern“, erklärt Prof. Kulozik, ärztlicher Direktor der Klinik.
Die Spezialsprechstunde wurde in das Einzelzentrum für seltene Bluterkrankungen des Zentrums für Seltene Erkrankungen am Universitätsklinikum Heidelberg integriert. Dort wurden jährlich bisher etwa 100 Kinder und Jugendliche mit angeborenen Anämien von dem interdisziplinären Team betreut. Bei den angeborenen Anämien liegt häufig ein Defekt oder Mangel des roten Blutfarbstoffs Hämoglobin zugrunde, dessen zentraler Bestandteil Eisen ist. Die häufigsten dieser Erbkrankheiten weltweit sind die Sichelzellkrankheit und die Thalassämie.
Diagnostik per DNA-Sequenzierung
Auch Störungen des Eisenstoffwechsels können Anämien zur Folge haben. Die genetischen Ursachen dieser Krankheit sind größtenteils unbekannt, vielfältig und schwer zu diagnostizieren. Der zugrundeliegende Defekt kann häufig nicht aufgeklärt werden, wodurch eine angemessene Behandlung erschwert wird. Die bislang einzige Therapie ist die Stammzelltransplantation. Zur Heilung erhalten die Betroffenen hier blutbildende Zellen eines fremden Spenders, die fortan funktionsfähiges Hämoglobin herstellen.
Um die unterschiedlichen Krankheitsursachen möglichst schnell zu identifizieren, stellte das Team um Kulozik und Muckenthaler eine Auswahl an diagnostischen Methoden zusammen. Neben anderen Untersuchungen werden je nach Ausprägung der Krankheit bestimmte, in Frage kommende Gene überprüft. Erhalten die Ärzte hier keine Treffer, wird eine aufwändige, genomweite Analyse angefordert, um Aufschluss über die genetischen Hintergründe der Erkrankungen zu erlangen. „Bei rund einem Drittel dieser Patienten mit einer bis dato unbekannten Anämieform werden wir auf diese Weise fündig“, erläutert Prof. Muckenthaler. „Zum Teil gibt uns das bereits Hinweise auf die geeignete Therapie. Zusätzlich versuchen wir im nächsten Schritt die durch diesen speziellen genetischen Defekt ausgelösten Krankheitsmechanismen in Zellkulturen oder im Tierversuch detailliert aufzuklären.“
Genetischer Defekt beeinflusst Therapie
Das Wissen um die genetischen Ursachen einer Anämie hat bereits jetzt einen enormen Einfluss auf die Therapie. Bei einem Patienten fielen bei der Geburt eine ausgeprägte Blutarmut und ein durch diese Belastung vergrößertes Herz auf. Die genetische Analyse zeigte eine noch nicht beschriebene Veränderung an einer bestimmten Stelle des Erbguts (DMT1-Gen), die den Eisentransport behindert. Ohne diese Erkenntnis wäre das Kind mit regelmäßigen Transfusionen behandelt worden, die zu einer lebensbedrohlichen Eisenüberladung in den Organen geführt hätte. „Durch die Gabe von EPO, das die Blutneubildung ankurbelt, haben sich die Blutwerte des Mädchens inzwischen normalisiert“, berichtet Prof. Kulozik.
Ein weiteres Beispiel verdeutlicht die Bedeutung der Erkenntnisse für die Therapie. Bei einem drei Monate alten Kind wurde eine Anämie diagnostiziert, die sich durch die Gabe von Eisen noch verschlechterte. Nach dem Erhalt von Transfusionen trat mit 18 Monaten anhaltendes Fieber auf. Untersuchungen ergaben, dass bei dem Patienten der Abbau des roten Blutfarbstoffs durch das Enzym Hämoxyenase 1 gestört ist, wodurch Eisenzufuhr und Transfusionen Gift sind für den Patienten. Das überschüssige Hämoglobin führt zu einer Überaktivierung bestimmter Immunzellen, Fieber und chronischen Entzündungen. Die überschüssige Immunreaktion wurde medikamentös eingestellt und regelmäßige Aderlässe helfen nun trotz Blutarmut.
Das Ziel der Wissenschaftler ist es nun, ein Register der deutschlandweiten Patienten angeborener Anämien, ihrer Erkrankungsmerkmale, genetischen Ursachen, Therapie und Therapieerfolg anzulegen. „Ein solches Register bietet erstmals die Möglichkeit, mehrere Patienten mit seltenen Erkrankungstypen zu vergleichen, möglicherweise typische Konstellationen zu identifizieren und bei ungeklärter Ursache die Therapie entsprechend anpassen zu können“, so Professor Muckenthaler.
Quelle: Pressemitteilung des Universitätsklinikums Heidelberg (21.02.2017)
Artikel teilen